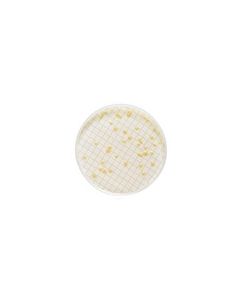
MXSMCTS48.jpg

The store will not work correctly when cookies are disabled.
- Termos de pesquisa relacionados
-
funil de separação 125 ml
-
funil de vidro 125 mm
-
funil de separac 125 ml
-
funil de separaca 125 ml
-
funil de separaco 125 ml

ADAPTADOR P/ CONEXÃO FONTE VÁCUO, LUER SLIP PARA 1/4" - 3/8" DIAM. INT. MILLIPORE
Modelo: XX6200004
R$ 1.432,81

CONEXÃO RETA EM PP P/MANGUEIRAS DE DIÂM.INT.3-5mm (EMB C/10 UND) BRAND
Modelo: RB152705
R$ 178,07

MILLIFLEX MEIO MAC CONKEY AGAR PARA BACTERIAS FERM. LACTOSE USP VALIDADE MINIMA:3 MESES (CX) MILLIPORE
Modelo: MXSMCMC24
R$ 744,28

MILLIFLEX MEIO M ENDO LES AGAR COLIFORMES CONF. STD METHODS VALIDADE MINIMA: 3 MESES (CX) MILLIPORE
Modelo: MXSMEND48
R$ 3.995,71

MONITOR 3 PECAS 2 MEMBRANAS DIAM. 37mm PORO 0,8um BRANCA, LISA P/ ANÁLISE GRAVIMÉTRICA - 50 UND
Modelo: MAWP037A0
R$ 1.567,09

CONECTOR DE MANGUEIRA 1/4 NPTM X 1/4 A 3/8 D.I. MILLIPORE - 02 UND
Modelo: XX4304704
R$ 432,63

PADRÃO INTERNO 8260 SURROGATE MIX 2,500 µg/mL RESTEK - 3 COMPONENTES, 1mL, CRM - ISO GUIDE 34
Modelo: RK30073
R$ 519,75

PAPEL FILTRO QUANTITATIVO GR 589/3 125 mm WHATMAN™ (CYTIVA) - CX/100 UND
Modelo: GE10300211
R$ 658,19

COLUNA LICHROSPHER 100 RP 18 5um 75x4mm LICHROCART EMB C/ 3 UND MERCK
Modelo: 1509870001
R$ 13.069,91

KIT CLORO E PH REAGENTE CLORO (CL2-1, CL2-2, CL2-3 ) MCOLORTEST REFIL MERCK-200 TESTES
Modelo: 1111570001
R$ 1.223,80

MILLIFLEX MEIO TRYPTIC SOY AGAR CONTAGEM TOTAL HETEROTROFICOS CONF. USP/EP VALIDADE MINIMA: 3 MESES (CX) MILLIPORE
Modelo: MXSMCTS48
R$ 3.880,87

COLUNA HPLC LICHROSPHER 100 RP 8 5um 125X4mm LICHROCART EMB C/ 3 UND MERCK
Modelo: 1509420001
R$ 14.521,38